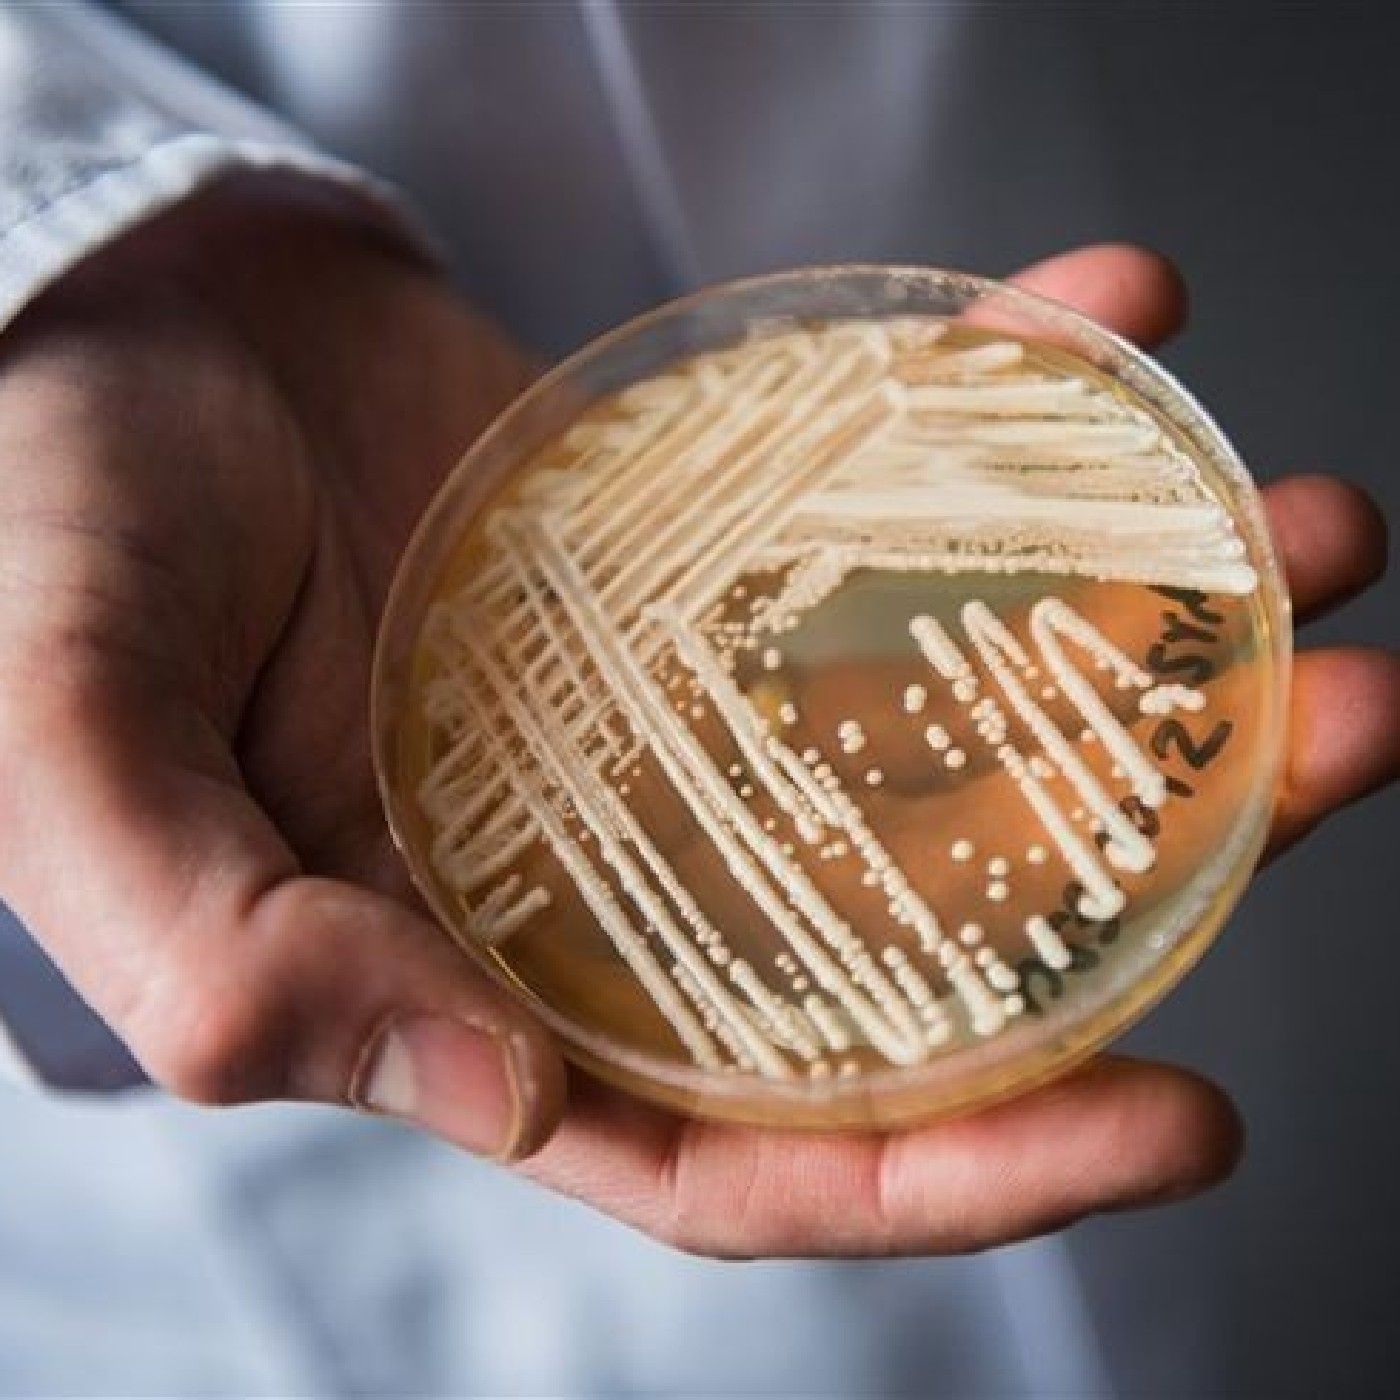

AAB
Por: Natalie Brenes
4 episodios disponibles